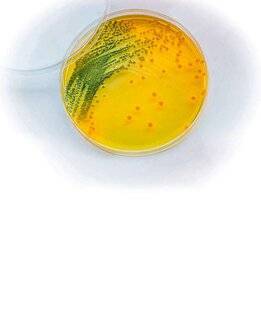
Science & Vie 1303 En mer, gare aux Vibrio

Êtes-vous sûr de vouloir effectuer cette action ?
Science & Vie - Le numéro 1303 du 25 mars 2026
Consultez le sommaire détaillé des articles parus dans ce numéro de Science & Vie.
Feuilletez un extrait de cette parution. Achetez le numéro au format papier ou numérique pour le retrouver sur votre espace client et l’application KiosqueMag.
KiosqueMag, la boutique officielle de Science & Vie propose l’accès le plus complet aux archives de la revue.

Au sommaire de ce numéro

L'algue Emiliania huxleyi fuit l'équateur
En mer, gare aux Vibrio

Le chargeur de piles jetables
Quelle est la différence entre essence et gazole ?

Encéphalites et maladie de Lyme atteignent le nord de l'Europe




































